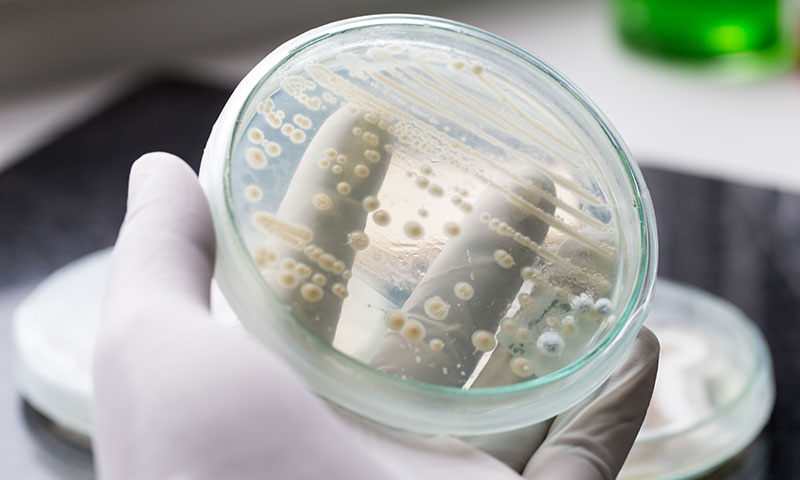
Main Content Intro Image

Article
Signs and symptoms of a concussion
Learn about how the Candida fungus spreads and who is at risk from a Children’s Health infectious disease specialist.
The Centers for Disease Control and Prevention (CDC) issued an alert that infections from the fungus Candida auris are increasing. Researchers have determined that the fungus has existed in Asia since the mid-1990s and has since spread worldwide. It is a common cause of yeast infections and is related to other yeast organisms.
Jeffrey Kahn, M.D., Infectious Disease Specialist, Division Director at Children's Health℠ and Professor at UT Southwestern, explains more about this fungus and its effects.
The fungus spreads by being in contact with a person who has the infection or the fungus in their environment. It can easily spread undetected from hospital to hospital as a person moves from one facility to another, and it is resistant to most antifungal medications.
To date, experts have identified Candida auris in 30 states across the United States, causing outbreaks in hospitals and other health care facilities.
Candida auris can spread easily because it doesn't cause any symptoms in generally healthy people. In immunocompromised people, however, an infection can cause serious complications.
Candida auris is generally not a concern for healthy people. Dr. Kahn explains that people with underlying health conditions are at the greatest risk of infection from the fungus. This includes those who:
Are immunocompromised, such as transplant patients or those receiving chemotherapy.
Have severe diabetes.
Use a breathing tube or feeding tube.
Use a catheter (tube to drain urine from the bladder).
In generally healthy people, the fungus doesn't cause any harm. "If you're otherwise healthy and come in contact with this organism, you will probably never know it," explains Dr. Kahn. Therefore, if your child is typically healthy with a normal immune system and visits the doctor for check-up appointment, you shouldn't worry too much about this fungus affecting them.
In high-risk people and when not properly managed, Candida auris infection can lead to:
Bloodstream infection (sepsis)
Infection around the catheter site
Pneumonia
Urinary tract infection (UTI)
Yes. According to the CDC, any invasive infections with Candida species can be fatal. However, many of those who have died with Candida auris infections had other serious illnesses or underlying conditions that increased their risk of death.
"If your child has a compromised immune system – such as having leukemia or another type of cancer and undergoing chemotherapy – you should be aware of the signs and symptoms of this fungal infection," says Dr. Kahn. You should take your child to see a doctor if:
They have an unusual catheter site, such as bleeding or discharge from the area.
They have a fever.
They have pain while urinating or trouble urinating.
Having one of these symptoms does not necessarily mean your child has a fungal infection. A doctor should see your child to rule out a serious medical problem.
Yes – the organism spreads from person to person. Dr. Kahn says it can be difficult to distinguish Candida auris from other yeast organisms and, therefore, can be difficult to put procedures in place to prevent its spread. "It's spread in environments where if you're not doing active surveillance, you're not going to know it's there," says Dr. Kahn.
In the hospital and other controlled health care settings, a person with Candida auris infection should be in isolation to reduce the risk of spreading the infection to others – especially to other people in the hospital who may be immunocompromised.
Researchers continue to learn more about Candida auris, and new information will be shared as it becomes available. The CDC is the best source of updated information.
Children's Health infectious disease specialists continue to closely monitor the spread of this fungus and other emerging infections that can be troublesome for children with compromised immune systems. Learn more about our infectious disease offerings.
SUBSCRIBE
Get personalized advice from Children’s Health experts sent straight to your inbox twice a month.